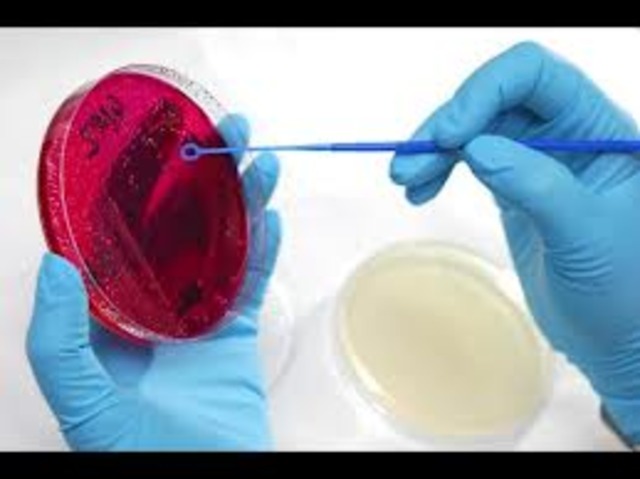
Paul Enrlich

-
Es considerado el primer anatomista griego y aún cuando en su época no se permitían las disecciones humanas, describió nuestra anatomía. Para hacerlo, practicó disecciones a un tipo de mono muy similar al hombre, el mono bárbaro, y por comparación con este mono, hizo una descripción de nuestra anatomía
-
Prestó más atención a los trabajos botánicos. En su Historia de las plantas se recogen algunas aportaciones originales como la observación de la germinación de la semilla
-
Inventaron el concepto del átomo
-
Conocido como el padre de la medicina. (460-550 a.n.e)
-
Construyó la idea del ser como algo inmutable. Influyo en platón y Aristóteles
-
propuso “Todo existe en estado de cambio continuo”
-
Todo ser humano proviene del agua
-
Reflejaron sofisticados sistemas independientes de la filosofía natural
-
Médico andalusí Avenzoar partidario de la disección experimental y la autopsia, que utilizó para demostrar que la enfermedad de la piel conocida como sarna era causada por un parásito, un descubrimiento que desestabilizaba la teoría del humorismo.
-
Escribió una enciclopedia farmacéutica que describía 1400 plantas, alimentos y medicinas, 300 de las cuales eran descubrimientos realizados por él mismo,una traducción al latín de su trabajo fue utilizada por biólogos y farmacéuticos europeos durante los siglos XVIII y XIX
-
Realizó una clasificación de las plantas según sus hojas y frutos, escribió una obra sobre animales en 26 tomos, descubrió la función de las antenas de las hormigas para su comunicación, la forma de tejer de las arañas, la necesidad de incubación de los huevos de las águilas, etc.
-
Médico árabe Ibn Nafis (1213-1288) fue unod e los primeros partidarios de la disección experimental y la autopsia, quien en 1242 descubrió la circulación pulmonar y la circulación coronaria,que forman la base del sistema circulatorio también describió el concepto de metabolismo,pulso, huesos, músculos, intestinos etc.
-
(1422-1519)
Aportaciones a la anatomía humana. -
Este médico originario de Bruselas, Bélgica, practicó disecciones humanas y describió de una mejor manera la anatomía humana. Sus resultados se encuentran en un libro llamado “Corpori Humani Fabrica”.
-
Contribuyó a explicar la circulación sanguínea, al demostrar que las venas presentan una serie de “puertas” o “válvulas” que impiden que la sangre se regrese por un mismo vaso
-
(1564-1642)
Pasos delmétodo científico. -
1564-1642
Primer tratado de anatomía. -
Médico y científico inglés, descubrió que el corazón era el encargado de bombear la sangre y además, descubrió el sentido de la circulación sanguínea
-
(1632-1723)
Elaboración de un microscopio mejor. -
A principios del siglo XIII fue uno de los primeros en utilizar el método científico en la botánica, introduciendo técnicas empíricas y experimentales en las pruebas, identificación de elementos de farmacopea.
-
Publicó una taxonomía básica para el mundo natural en 1735 variaciones de la misma se han seguido utilizando hasta la actualidad, y en los años 1750 introdujo la nomenclatura binominal para todas sus especies
-
(1744-1829)
Dio el nombre de BIOLOGIA. -
Analizó la relación entre organismos y su ambiente . El trabajo de Humboldt estableció las bases de la biogeografía e inspiró a varias generaciones de científicos
-
Descrito el núcleo celular.
-
Empezaron a promover la teoría según la cual la unidad básica de los organismos es la célula, las células individuales tienen todas las características de la vida, aunque se opusieran a la idea que todas las células proceden de otras células.
-
Descubrimiento delos grupos sanguíneos; A, B, AB, O.
-
Demostraciónde la existencia de hormonas.
-
Concepto de lainteracción genética.
-
descubrimientos de la estructura celular yen células nerviosas
-
Determinación del papel de los anticuerpos en la defensa del organismo.
-
Estudios sobre elmapeo cromosómico y herencia ligada alsexo.
-
Teoría del origen dela vida a través de la fotosíntesis abiótica.
-
Descubrimiento delos efectos de los antibióticos
-
descubrimiento de lapenicilina
-
Identificación de laadrenalina de impulso nervioso.
-
Establecimiento del ciclo que forma parte de la respiración celular.
-
Descubrimiento de los trasposones. (1940-1950)
-
Establecimiento de la relación de los genes en la proteínas (gen-enzima).
-
Determinación de ADN como portador de la herencia.
-
Empieza el desarrollo de investigaciones en Mexico.Se han hecho grandes avances con la ecología, para la corrección de la problemática ambiental.
-
Investigación sobre lasíntesis abiótica, apoyo a la teoría de Oparin.
-
Descubrimiento de ladoble hélice del ADN.
-
Descubrimiento del ADN.
-
Desarrollo de lavacuna trivalente contra la poliomielitis.
-
Descubrimiento del ARNpolimerasa.
-
Descubrimiento del sistema de regulacióngénica: el operón.
-
Descifrado del códigogenético.
-
Determinación delproceso de obtención del ATP en las membranas mitocondriales
-
El metabolismo delípidos.
-
Se funda Greenpeace, organización internacional que se inicia con acciones contra los ensayos nucleares en Alaska
-
Descubrimiento del daño a la capa de ozono debido al uso de CFC
-
Síntesis de anticuerpos monoclonales utilizadas para pruebas dediagnostico.
-
Descubrimiento de los oncogenes y otrosfactores causantes del cáncer.
-
Síntesis, porprimera vez, de proteínas humanas enbacterias a través de ingeniería genética.
-
Descubrimiento del VIH causante del SIDA.
-
Desarrollo de laprueba PCR, para pruebas de identidad porel ADN.
-
Redescubrimiento de las leyes de Mendel.
-
Descubrimiento de la base genética para la identificación de olores.
-
Descubrimiento decanales en las membranas celulares,llamadas aquaporinas facilitan la entrada deagua a la célula.
-
Consorcio del Proyecto del GenomaHumano(PGH) : Conclusión de PGH paraidentificar la secuencia de bases del ADN
-
la optogenética,usando una combinación de manipulacióngenética y pulsos simples de luz, haconseguido controlar células del cerebro deforma sorprendentemente precisa, alterandola actividad cerebral e incluso elcomportamiento en animales
-
(384-322 a.n.e)
Clasificación de plantas y animales. -
En zoología, por ejemplo, fue un erudito afroárabe describió algunas de las primeras ideas evolutivas. (781-869)
-
El médico persa Avicena (980-1037) introdujo los ensayos clínicos y la farmacología clínica en su enciclopedia el canon de medicina, que se utilizó como texto de referencia para la enseñanza médica europea hasta el siglo XVII
-
Postuló que los seres vivos; se han preservado desde el principio de su existencia cada raza en particular, bien por su destreza, por su valor o por su velocidad .
Want to make a timeline like this?
Use Timetoast to turn dates, events, milestones, and phases into a clear visual timeline you can build and share. Timetoast is a timeline maker for work, school, research, and stories.